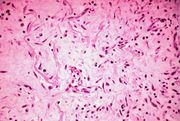

File list
This special page shows all uploaded files.
| Date | Name | Thumbnail | Size | User | Description | Versions |
|---|---|---|---|---|---|---|
| 04:16, 19 August 2013 | IPLab3ChronicPepticUlcer7.jpg (file) |  |
53 KB | Seung Park | This high-power photomicrograph of the ulcer base demonstrates plump, activated fibroblasts and endothelial cells (arrows) within the granulation tissue that makes up the base of the ulcer. There are inflammatory cells (primarily lymphocytes) within th... | 1 |
| 04:16, 19 August 2013 | IPLab3ChronicPepticUlcer8.jpg (file) |  |
50 KB | Seung Park | This low-power photomicrograph demonstrates the healing reaction in the base of this ulcer. The base of the ulcer is at the left-hand side of the image and the serosal surface is at the right. Note the fibrous connective tissue within the wall of the s... | 1 |
| 04:17, 19 August 2013 | IPLab3ChronicPepticUlcer9.jpg (file) | |
50 KB | Seung Park | This high-power photomicrograph demonstrates the granulation tissue within the base of the ulcer. | 1 |
| 04:17, 19 August 2013 | IPLab3ChronicPepticUlcer10.jpg (file) |  |
65 KB | Seung Park | This is a photomicrograph of the serosal surface (1) from a section of stomach near the ulcer. Note that the inflammatory reaction extends out to the serosa. | 1 |
| 04:17, 19 August 2013 | IPLab3ChronicPepticUlcer11.jpg (file) |  |
73 KB | Seung Park | This is a trichrome-stained section of tissue demonstrating fibrous connective tissue scar formation (blue color) in this lesion. The surface of the ulcer is at the left-hand side of the image. There is a layer of inflammatory cells and RBCs on the sur... | 1 |
| 04:21, 19 August 2013 | IPLab3BrainInfarction1.jpg (file) |  |
37 KB | Seung Park | This is a gross photograph of the brain which contains two areas of infarction (arrows). | 1 |
| 04:22, 19 August 2013 | IPLab3BrainInfarction2.jpg (file) |  |
32 KB | Seung Park | This is a gross photograph of a cross-section of brain demonstrating the areas of infarction (arrows). | 1 |
| 04:22, 19 August 2013 | IPLab3BrainInfarction3.jpg (file) |  |
51 KB | Seung Park | This is a low-power photomicrograph of brain at the edge of the infarct. Note the loss of brain parenchyma (arrows). | 1 |
| 04:22, 19 August 2013 | IPLab3BrainInfarction4.jpg (file) |  |
68 KB | Seung Park | This is a photomicrograph of the edge of the infarct. Note the numerous inflammatory cells in the brain parenchyma and adjacent to the remaining brain tissue (arrows). | 1 |
| 04:22, 19 August 2013 | IPLab3BrainInfarction5.jpg (file) |  |
51 KB | Seung Park | This is a higher-power photomicrograph of the previous image showing that the inflammatory cells (arrows) are primarily macrophages and microglia which have phagocytosed the dead brain tissue. | 1 |
| 04:22, 19 August 2013 | IPLab3BrainInfarction6.jpg (file) |  |
55 KB | Seung Park | This is a photomicrograph of brain tissue adjacent to the area of infarction. There are numerous activated gemistocytic astrocytes (arrows). | 1 |
| 04:23, 19 August 2013 | IPLab3BrainInfarction7.jpg (file) |  |
50 KB | Seung Park | This is a photomicrograph of the edge of the infarct. The macrophages that are full of brain tissue (“gitter cells”) are at the top of the image (arrows) and the brain parenchyma containing gemistocytic astrocytes is at the bottom. | 1 |
| 04:23, 19 August 2013 | IPLab3BrainInfarction8.jpg (file) |  |
28 KB | Seung Park | This is a high-power photomicrograph of gitter cells (arrows). | 1 |
| 04:23, 19 August 2013 | IPLab3BrainInfarction9.jpg (file) |  |
43 KB | Seung Park | This is a photomicrograph of the edge of the infarct. Note the gitter cells, gemistocytic astrocytes, and some hemosiderin-laden macrophages (arrows). | 1 |
| 04:24, 19 August 2013 | IPLab3BrainInfarction10.jpg (file) |  |
56 KB | Seung Park | This is a gross photograph of a brain from another patient with an old healed infarct. Note the meninges overlying the infarcted region (arrow). | 1 |
| 04:24, 19 August 2013 | IPLab3BrainInfarction11.jpg (file) |  |
56 KB | Seung Park | This is a closer view of the brain demonstrating an old healed infarct with the meninges containing blood vessels (arrow) overlying the infarcted region. | 1 |
| 04:29, 19 August 2013 | IPLab3AcuteMyocardialInfarction1.jpg (file) |  |
36 KB | Seung Park | This is a low-power photomicrograph of infarcted heart. There is a layer of surviving myocardial tissue (1) along the epicardium and then a blue line (2) which represents the accumulation of inflammatory cells at the border of the infarct. There is thr... | 1 |
| 04:29, 19 August 2013 | IPLab3AcuteMyocardialInfarction2.jpg (file) |  |
60 KB | Seung Park | This is a higher-power photomicrograph which shows more clearly the viable tissue along the epicardium (1), the blue line of inflammatory cells (2), and the infarcted myocardium (3). | 1 |
| 04:29, 19 August 2013 | IPLab3AcuteMyocardialInfarction3.jpg (file) |  |
83 KB | Seung Park | This is a photomicrograph of the edge of the infarct with normal tissue on the left (1). The accumulation of inflammatory cells (2) is at the edge of the infarcted tissue (3). | 1 |
| 04:30, 19 August 2013 | IPLab3AcuteMyocardialInfarction4.jpg (file) |  |
79 KB | Seung Park | This is a higher-power photomicrograph of the edge of the infarct. The accumulation of inflammatory cells is on the left (1) and the infarcted tissue is on the right (2). Note that intact cells can be seen in the infarct but there are no nuclei. | 1 |
| 04:30, 19 August 2013 | IPLab3AcuteMyocardialInfarction5.jpg (file) |  |
68 KB | Seung Park | This is a high-power photomicrograph of another area of this section. There are several hypereosinophilic cells within this section (arrows). | 1 |
| 04:30, 19 August 2013 | IPLab3AcuteMyocardialInfarction6.jpg (file) |  |
79 KB | Seung Park | This is a low-power photomicrograph of a mural thrombus (1) adherent to the endocardial surface (arrows). | 1 |
| 04:30, 19 August 2013 | IPLab3AcuteMyocardialInfarction7.jpg (file) |  |
88 KB | Seung Park | This is a photomicrograph of the lines of Zahn. Pale areas (1) represent platelets with some fibrin and the darker lines (2) represent RBCs and leukocytes enmeshed in fibrin strands. | 1 |
| 04:36, 19 August 2013 | IPLab3HealedMyocardialInfarction1.jpg (file) |  |
25 KB | Seung Park | This is a gross photograph of a heart with areas of old healed myocardial infarction (scars) outlined by arrows. | 1 |
| 04:36, 19 August 2013 | IPLab3HealedMyocardialInfarction2.jpg (file) |  |
75 KB | Seung Park | This is a low-power photomicrograph of a healed myocardial infarction with a fibrous scar. Remaining normal tissue is on the left (1) and the fibrous connective tissue scar is on the right (2). | 1 |
| 04:37, 19 August 2013 | IPLab3HealedMyocardialInfarction3.jpg (file) |  |
71 KB | Seung Park | This is a higher-power photomicrograph of a healed myocardial infarction with a fibrous scar. Remaining normal tissue is at the top (1) and the fibrous connective tissue scar is at the bottom (2). Note the presence of occasional hypereosinophilic myocy... | 1 |
| 04:37, 19 August 2013 | IPLab3HealedMyocardialInfarction4.jpg (file) |  |
61 KB | Seung Park | This is another high-power photomicrograph of a healed myocardial infarction. Note the remaining normal myocytes (1), the fibrous connective tissue (2), and occasional hypereosinophilic myocytes indicating recent acute ischemic injury (arrow). | 1 |
| 04:37, 19 August 2013 | IPLab3HealedMyocardialInfarction5.jpg (file) |  |
36 KB | Seung Park | This is a high-power photomicrograph of a different region of this healed MI. Note the chronic inflammatory reaction (arrows) in this region suggesting that there had been ischemic injury to this area within the last several weeks to months. | 1 |
| 04:38, 19 August 2013 | IPLab3HealedMyocardialInfarction6.jpg (file) |  |
70 KB | Seung Park | This is a photomicrograph of a trichrome-stained section from a heart with an acute myocardial infarction. Note that there is little fibrous connective tissue. It is too early for scar formation to have taken place in this acute lesion. | 1 |
| 04:38, 19 August 2013 | IPLab3HealedMyocardialInfarction7.jpg (file) |  |
71 KB | Seung Park | This is a photomicrograph of a trichrome-stained section of heart containing an old healed myocardial infarction. The scar is composed of mature fibrous connective tissue (arrows). | 1 |
| 04:39, 19 August 2013 | IPLab3HealedMyocardialInfarction8.jpg (file) |  |
73 KB | Seung Park | This is a higher-power photomicrograph of a trichrome-stained section of heart containing an old healed MI. The scar tissue (mature fibrous connective tissue) is stained blue. | 1 |
| 15:27, 19 August 2013 | IPLab2Hyperplasia1.jpg (file) |  |
58 KB | Peter Anderson | This photograph shows the autopsy specimen from this patient. Included are kidneys (1), ureters (2), bladder (3) (which has been opened), and enlarged prostate (4). Note that the bladder mucosa has multiple trabeculae and the bladder mucosa is hyperemi... | 1 |
| 15:27, 19 August 2013 | IPLab2Hyperplasia2.jpg (file) |  |
44 KB | Peter Anderson | This is a close-up of the prostate from this same patient. Note the nodularity of the tissue (1) and the enlargement of the gland. Enlargement of the prostate leads to compression of the urethra as it passes through (2) the gland. | 1 |
| 15:28, 19 August 2013 | IPLab2Hyperplasia3.jpg (file) |  |
48 KB | Peter Anderson | This is a low-power photomicrograph showing hyperplastic prostate on the left (1) and normal prostate on the right (2). At this power, dilated glands are visible in the section of hyperplastic prostate. | 1 |
| 15:28, 19 August 2013 | IPLab2Hyperplasia4.jpg (file) |  |
69 KB | Peter Anderson | The dilated glands (arrows) make up the major portion of the prostate tissue and there is compression of the stroma. | 1 |
| 15:28, 19 August 2013 | IPLab2Hyperplasia5.jpg (file) |  |
86 KB | Peter Anderson | Note these glands, which exhibit hyperplasia of the glandular epithelium. The infolding of the glandular epithelial cells forms papillary projections (arrows) into the lumen of the gland. | 1 |
| 15:28, 19 August 2013 | IPLab2Hyperplasia6.jpg (file) |  |
61 KB | Peter Anderson | Cystic dilatation of glands is present in this photomicrograph. Notice the accumulation of secretory material inside the glands (arrows) and compression (thinning) of the lining epithelium. | 1 |
| 15:29, 19 August 2013 | IPLab2Hyperplasia7.jpg (file) |  |
74 KB | Peter Anderson | A higher-power view shows the papillary folds (arrows) produced by the hyperplastic epithelium projecting into the lumen of the gland. While these papillary folds project into the lumen of the gland, there is no extension through the glandular basement... | 1 |
| 15:29, 19 August 2013 | IPLab2Hyperplasia8.jpg (file) |  |
53 KB | Peter Anderson | This is a higher-power photomicrograph of papillary folds of hyperplastic epithelium (arrows). | 1 |
| 15:29, 19 August 2013 | IPLab2Hyperplasia9.jpg (file) |  |
37 KB | Peter Anderson | This kidney was removed from another autopsy patient who had prostatic hyperplasia resulting in marked urinary retention and back-flow of urine from the bladder into the ureters and renal pelvis. The increased pressure inside the renal pelvis resulted ... | 1 |
| 15:39, 19 August 2013 | IPLab2Metaplasia1.jpg (file) |  |
26 KB | Peter Anderson | This is a low-power photomicrograph showing the full cortical and medullary thickness of the kidney. Note that there is a dilated calyx containing some red blood cells in the center of the section (arrow). The cortex is markedly thin and has severe les... | 1 |
| 15:40, 19 August 2013 | IPLab2Metaplasia2.jpg (file) |  |
41 KB | Peter Anderson | his high-power photomicrograph demonstrates the transitional epithelium lining the renal calyx (1) and the junction (transition zone) to a thicker hyperplastic epithelium (2). Note the inflammatory cells and increased vascular response in the stromal t... | 1 |
| 15:41, 19 August 2013 | IPLab2Metaplasia3.jpg (file) |  |
64 KB | Peter Anderson | A higher-power view shows the junction of normal epithelium (1) with hyperplastic transitional epithelium (2). Note the inflammatory cells in the subepithelial tissue. | 1 |
| 15:43, 19 August 2013 | IPLab2Metaplasia4.jpg (file) |  |
46 KB | Peter Anderson | This is a higher-power photomicrograph of the junction of normal epithelium (1) with hyperplastic transitional epithelium (2). | 1 |
| 15:44, 19 August 2013 | IPLab2Metaplasia5.jpg (file) |  |
76 KB | Peter Anderson | In areas adjacent to the normal transitional epithelium, there are areas of epithelium (arrows) where the epithelial cells have the character of normal squamous epithelium as found in the dermis. However, squamous epithelium is not normal in the renal ... | 1 |
| 15:45, 19 August 2013 | IPLab2Metaplasia6.jpg (file) |  |
67 KB | Peter Anderson | A high-power photomicrograph of the squamous epithelium shows inflammatory cells in the subepithelial tissue and the formation of keratinized epithelium (arrows). | 1 |
| 15:45, 19 August 2013 | IPLab2Metaplasia7.jpg (file) |  |
57 KB | Peter Anderson | This is a photomicrograph of the trachea from a smoker. Note that the columnar ciliated epithelium has been replaced by squamous epithelium. | 1 |
| 16:00, 19 August 2013 | IPLab2Atrophy1.jpg (file) |  |
23 KB | Peter Anderson | This is a gross photograph of an atrophied testis (arrows). | 1 |
| 16:01, 19 August 2013 | IPLab2Atrophy2.jpg (file) |  |
53 KB | Peter Anderson | This is a low-power photomicrograph of an atrophic testis. Attached to the testis are several vessels (arrow) which are part of the epididymis and the vas deferens. | 1 |
| 16:01, 19 August 2013 | IPLab2Atrophy3.jpg (file) |  |
65 KB | Peter Anderson | This is a higher-power photomicrograph of an atrophic testis. In this section there are seminiferous tubules with viable cells (1) although there are no visible spermatocytes. Other seminiferous tubules are completely acellular and have a pale pink hya... | 1 |